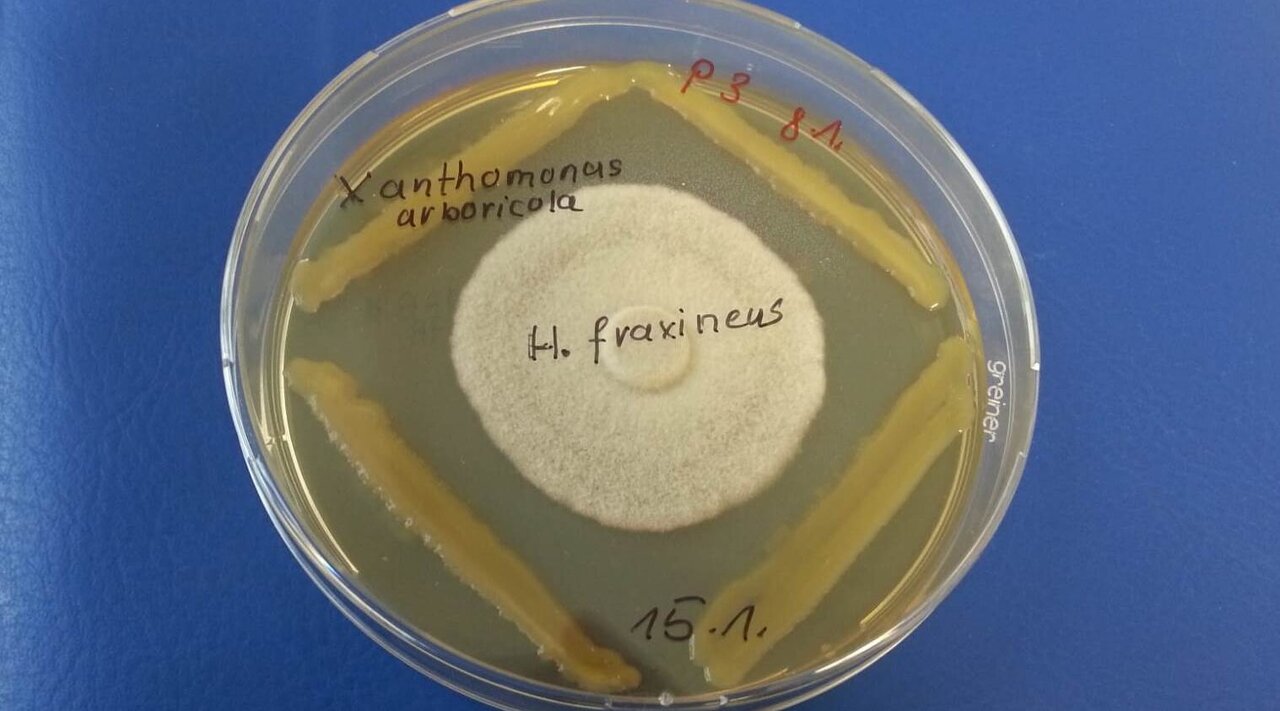

Project
Analyses of the microbiome for identification and selection of potential antagonists and their evaluation in planta against the causative agent of ash dieback
Analyses of the microbiome for identification and selection of potential antagonists and their evaluation in planta against the causative agent of ash dieback
Analyses of the microbiome for identification and selection of potential antagonists and their evaluation in planta against the causative agent of ash dieback
Background and Objective
Ash dieback caused by Hymenoscyphus fraxineus has spread since middle of the nineties across Europe and threatens to destroy ash forests. The biological control of this disease by microbial antagonists, which directly attack and/or suppress the pathogen by competition, represents a promising possibility to inhibit ash dieback. The use of suitable microorganisms may provide synergistic effects in combination with the selection of resistant plant clones. The project aims to develop a biological control system on the basis of epi-and endophytic isolates, which are able to persist in ash plants. Promising bacteria and fungi are selected based on the comparison of the microbiomes of infected and resistant plants applying next generation sequencing. The selected microbial isolates will be genetically characterized and evaluated with regard to their antagonistic potential. Finally, antagonistic isolates and/or microbial consortia will be evaluated in planta. This promising approach offers the chance of applying antagonistic microorganisms for the control of ash dieback in seed orchards and forests.
Approach
The project aims to develop a biological control system on the basis of epi-and endophytic isolates, which are able to persist in ash plants. Promising bacteria and fungi are selected based on the comparison of the microbiomes of infected and resistant plants applying next generation sequencing. The selected microbial isolates will be genetically characterized and evaluated with regard to their antagonistic potential. Finally, antagonistic isolates and/or microbial consortia will be evaluated in planta. This promising approach offers the chance of applying antagonistic microorganisms for the control of ash dieback in seed orchards and forests.
Results
The analysis of the microbiomes of tolerant and susceptible ash trees showed a high diversity of bacteria and fungi. Together with the classification of over 4000 isolates, a complete picture of the differences between tolerant and susceptible trees emerged. A number of taxonomic groups specific to tolerant ash trees could be revealed. Especially isolates of the phylotypes Luteimonas fraxinea and Aureimonas "altamirensis" were identified as promising candidates for the control of H. fraxineus based on colonisation resistance. Together with sub-project 1, more than 30 isolates/consortia were tested by shoot inoculation on ash seedlings. The strains Bacillus velezensis A4P130, L. fraxinea D4P002, A. "altamirensis" C2P003 and Paenibacillus "lautus" B3P038 showed clear effects over a period of three years. In parallel to shoot inoculation, seed inoculation was tested, but did not prove practical. Analysis of the microbiome in two plant tests showed a significant change in bacterial communities after inoculation with P. "lautus" B3P038, L. fraxinea D4P002 and A. "altermirensis" C2P003 as well as with the consortium of D4P002 and C2P003. This suggests that strains without direct antagonistic activity also contribute to pathogen defence via colonisation resistance or indirectly via modification of the ash microbiome. The functional genome analysis of L. fraxinea D4P002 revealed numerous traits associated with the ability to defend against pathogens or the expression of colonisation resistance. In summary, in collaboration with sub-project 1, four bacterial strains and a consortium were isolated, characterised and made available as candidates for the biological control of ash dieback.
Involved Thünen-Partners
Involved external Thünen-Partners
- Leibniz-Zentrum für Agrarlandschaftsforschung (ZALF) e.V.
(Müncheberg, Deutschland)
Funding Body
-
Fachagentur Nachwachsende Rohstoffe e.V. (FNR)
(national, öffentlich)
Duration
6.2017 - 6.2022
More Information
Funding program: FNR
Project status:
finished
![[Translate to English:] [Translate to English:]](/media/_processed_/f/3/csm_2022_Titelbild_gross2_Saatgut_in_Hand_9ffb8f5748.jpg)
![[Translate to English:] [Translate to English:]](/media/_processed_/f/3/csm_2022_Titelbild_gross2_Saatgut_in_Hand_c17270fcc0.jpg)




